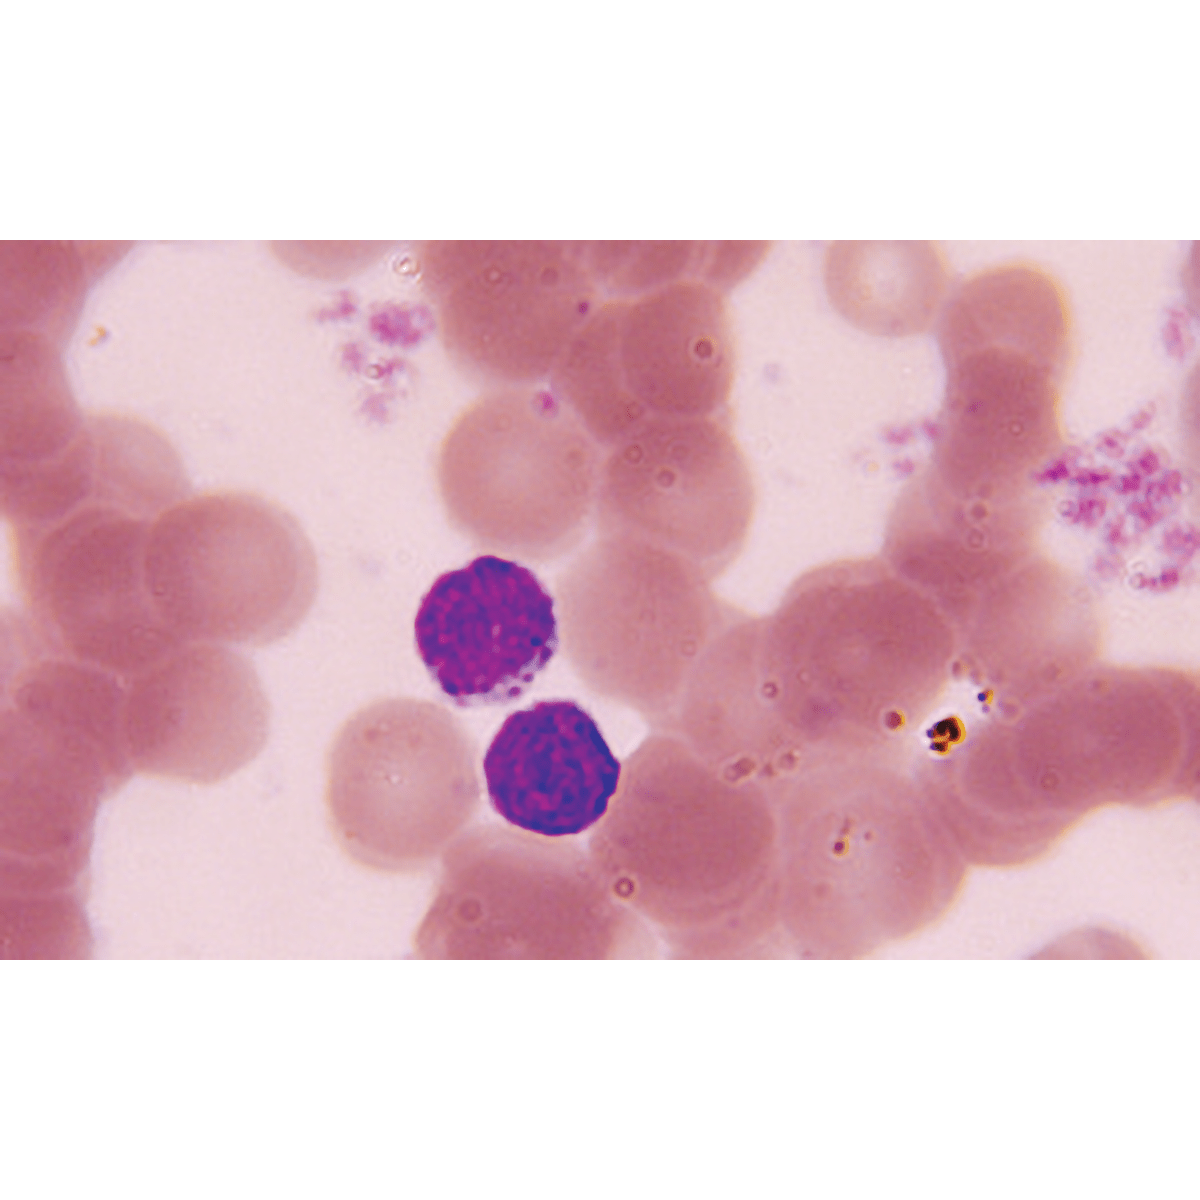

StainRITE® May-Grünwald Stain Solution
Product Number:
-
24981
Product Description
May-Grünwald Stain Solution is a classic hematology stain that produces dense coloration in the staining of peripheral blood smears and bone marrows.Stain Results:
Nuclei, Bacteria - Blue
Cytoplasm - Pink-Rose
To be used in conjunction with our Giemsa Stain (for May-Grünwald), Cat. #25038